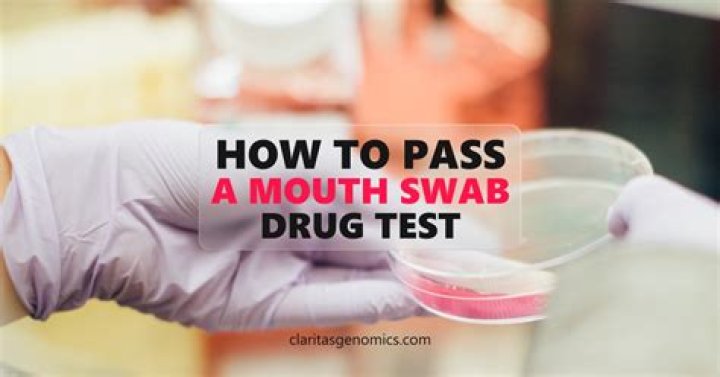

How To Pass A Mouth Swab
 Isabella Browning
Isabella Browning
How To Pass A Mouth Swab
What is an ■■■■ test? ۔
I have just learned that I have to take an ■■■■ exam and I know I will not pass. I cheated on the audition while drinking The Stuff, so I was wondering if it would work on the audition as well. So my job depends on that. PLEEEEEAAAAAAASSSEEE Answer! And I know the best way to try, not you, but it's been a while :(
Things you will need:
1 bottle of Mayotte Wash.
1 foot detox pad.
1 detox drink.
1. Use a toxin-removing mouthwash for ■■■■■■■■■ testing. Keep a mouthwash around the mouth for 5 to 30 minutes during the test.
2. Use a detox footpad for a few days. This test will help eliminate any toxins and indications for use.
3. Drink 24 oz. Glue water with two detox drinks before the test to remove toxins from the saliva.
4. Drinking cranberry juice and practicing sweating will help you detox faster.
5. Visit the sauna for a sleep therapy session that will help eliminate sweat toxins.
6. Take three to four aspirins before the test. Sometimes they act like a mask and cover your entire system.
7. Drink 8 ounces. Water within 24 hours to remove toxins.
8. Stop taking anything that can lead to false positive results. Excessive use of poppy seeds, some over-the-counter medications, and some over-the-counter medications can lead to false positive results. Inform the candidate about any prescription or overdose medication.
9. Use a test kit to test your system and see results. If the test shows usage, keep using the cleaning method described before running the test.
S cheek test.
This test is done when the company does not care whether the person smokes or not. Saliva is sucked for only 3 days. As long as you don't smoke for 3 days, the evidence is good. Don't waste your money on hygiene items, get plenty of water.
Is it true that if you smoke for 3 days, if you do not smoke, you can test with the letter S in your mouth? Are there companies that don't care? Getting a job, smoking me. My life almost saved me.
Aspirin chewing works like a charm, you can drink it and move on.
If you hear gargling with a 6-in-1 list ... you always drink.
How To Pass A Mouth Swab
How To Pass A Mouth Swab
What if you smoke at 48 and drink a little?
Smoke every day)
Glad you already know the answer. If your work really depends on it, stop using it.
How To Pass A Mouth Swab
How To Pass A Mouth Swab
What is an ■■■■ test? 3
I just found out I have to take an ■■■■ exam and I know I won't pass. I cheated during the test while drinking The Stuff, so I was wondering if it would work during the test. So my job depends on that. PLEEEEEEAAAAAAASSSEEE Answer! And I know the best way to try it, isn't it, but it's been a while :(
Things you will need:
1 bottle of detoxifying mouthwash
1 foot detox pad
1 detox drink
1. For a pop-up test, use a mouthwash that removes toxins if the mouthwash is passed around the mouth for 3 minutes, 5 to 30 minutes during the test.
2. Use the Foot Detox Pad as a test for a few days to remove toxins and any instructions for use.
3. Drink 24 ounces. Gl water with two detox drinks before testing to remove saliva toxins.
4. Drinking cranberry juice and working with sweat during exercise will help you detox faster.
5. Go to the sauna for a sleep therapy session that will help eliminate toxins.
6. Take three to four aspirins before testing; Sometimes they act as a mask and cover your entire system.
7. Drink 8 ounces. Give water within 24 hours to remove toxins.
8. Stop using anything that can cause false positives. Excessive use of poppy seeds, some over-the-counter medications, and some over-the-counter medications can lead to false positive results. Inform the candidate about any prescription or overdose medication they are taking.
9. Use a test kit to test your system and see results. If the test shows use, continue using the cleaning method described before running the test.
This test is done when the company does not care if you smoke or not. Saliva is sucked for only 3 days. As long as you don't smoke for 3 days, the evidence is good. Don't waste your money on cleaning products, just drink plenty of water.
How To Pass A Mouth Swab
How To Pass A Mouth Swab
Is it true that if you smoke for 3 days, if you do not smoke, you can test with the letter s in your mouth? There are companies that don't care, wow all this, wow, you can't believe how much it costs to get my smoking job. My life almost saved me
Aspirin chewing works like a charm, you can smoke and continue smoking.
I've heard that if you gargle with a 6-in-1 list, you use it all the time.
What if you smoked at 48 ur and drank a little?
Smoke Net Dog Every Day)
How To Pass A Mouth Swab
How To Pass A Mouth Swab
Glad you already know the answer. If your work really depends on it, get out. If not, go to the manager and talk to him, he has a lot to buy. Cold there
Here's the idea: more s?



